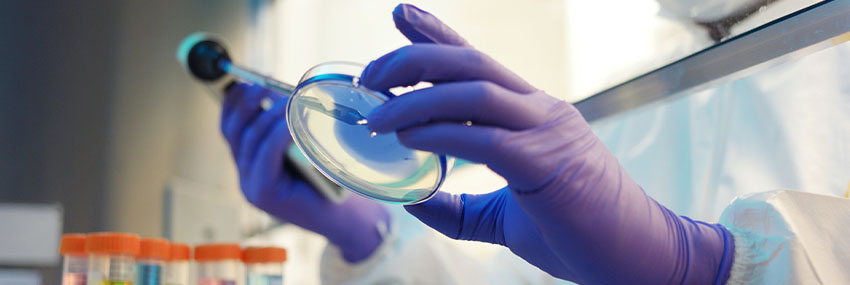

Graduate Program Highlights
Purdue’s graduate program offers both Master of Science (MS) and PhD degrees in occupational and environmental health science. The MS program is accredited by the Applied Science Accreditation Commission of ABET https://www.abet.org.
For a complete description of our educational objectives, student outcomes, and enrollment and graduation data, visit our accreditation page.
Application Deadlines
|
Fall |
Spring |
Summer |
|
|---|---|---|---|
|
MS student |
Dec. 1 |
Special cases only |
Special cases only |
|
PhD student |
Dec. 1 |
Special cases only |
Special cases only |
Program Details
Master of Science Program
- Program length is two years.
- Thesis and non-thesis options are available.
- Undergraduate cumulative grade point average (GPA) must be a minimum of 3.0 or equivalent.
- Graduate Record Examination (GRE) results are required — 300 or higher preferred.
- Most students secure jobs before graduation.
- Excellent career opportunities are available.
- Undergraduate degree in science or engineering with at least one year of college-level coursework in biology, chemistry, and physics preferred
For more information, see the plans of study for our thesis and non-thesis program options.
PhD Program
- Program length is 3-5 years.
- Undergraduate cumulative grade point average (GPA) must be a minimum of 3.5 or equivalent.
- Graduate Record Examination (GRE) results are required — 300 or higher preferred.
- NIOSH training grant funding is available but not guaranteed.
- Undergraduate degree in science or engineering with at least one year of college-level coursework in biology, chemistry, and physics preferred
For more information, see our PhD plan of study.
NOTE: International applicants whose native language is not English are required to provide proof of English proficiency for admission to degree, certificate, non-degree and teacher license graduate programs. For more information, see our English proficiency requirements.
